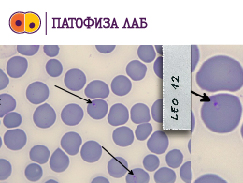

Клинике и лабораторије
Лабораторије
Лабораторија за генетику животиња
Катедра за биологију
| Радно време | 08.00-15.00 |
|---|---|
| Телефон |
(064) 3581166 (011) 3671 721 |
Презентација лабораторије: http://biologija.vet.bg.ac.rs/laboratorija/
Лабораторија за патологију
Катедра за патологију
| Радно време | 08.00-19.00 |
|---|---|
| Телефон | 011/3615-436 лок. 321 |
Презентација лабораторије: http://patologija.vet.bg.ac.rs/Usluge.html
Лабораторија за микробиологију
Катедра за микробиологију
| Радно време | 08.00-15.00 |
|---|---|
| Телефон | 011/2685-744 |
Презентација лабораторије: http://mikrobiologija.vet.bg.ac.rs



Лабораторија за испитивање хране за животиње
Катедра за исхрану
| Радно време | 08.00-15.00 |
|---|---|
| Телефон | 011/3615-436 лок. 345 |
Презентација лабораторије: http://ishrana.vet.bg.ac.rs/
Лабораторија за испитивање намирница анималног порекла
Катедра за хигијену и технологију намирница анималног порекла
| Радно време | 08.00-15.00 |
|---|---|
| Телефон | 011/3615-436 лок. 348 |
Лабораторија за паразитологију
Катедра за паразитологију
| Радно време | 08.00-15.00 |
|---|---|
| Телефон | 011/3615-436 лок. 302 |
Лабораторија за гамаспектрометрију
Катедра за радиологију и радијациону хигијену
| Радно време | 08.00-15.00 |
|---|---|
| Телефон | 062 8868229 |
Лабораторија за дијагностику заразних болести животиња и болести пчела
Катедра за заразне болести животиња и болести пчела
| Радно време | 08.00-15.00 |
|---|---|
| Телефон | 011/2685-080 |
Лабораторија за клиничку хематологију и биохемију
Катедра за патолошку физиологију
Радно време |
Радним данима: 9-14 и 16-20 часова Суботом: 9-14 часова Недељом: 9-14 часова |
|---|---|
| Телефон | 011/2685-052 062/803-8426 |